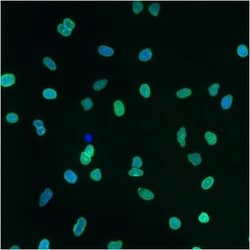
Lamin A + C Antibody (mab636), Novus Biologicals:Antibodies:Primary Antibodies

missing translation for 'onlineSavingsMsg'
Learn More
Learn More
Lamin A + C Antibody (mab636), Novus Biologicals™
Mouse Monoclonal Antibody has been used in 2 publications
213.00€
Specifications
| Antigen | Lamin A + C |
|---|---|
| Clone | mab636 |
| Dilution | Western Blot 1:100 - 1:2000, Immunohistochemistry 1:100, Immunocytochemistry/Immunofluorescence 1:100, Immunohistochemistry-Frozen 1:100 |
| Applications | Western Blot |
| Classification | Monoclonal |
Description
Lamin A + C Monoclonal specifically detects Lamin A + C in Human, Mouse, Rat, Porcine, Bovine samples. It is validated for Western Blot, Immunohistochemistry, Immunocytochemistry/Immunofluorescence, Immunohistochemistry-Frozen.Specifications
| Lamin A + C | |
| Western Blot 1:100 - 1:2000, Immunohistochemistry 1:100, Immunocytochemistry/Immunofluorescence 1:100, Immunohistochemistry-Frozen 1:100 | |
| Monoclonal | |
| Supernatant | |
| RUO | |
| Tissue culture supernatant with 0.05% Sodium Azide | |
| CDCD1, CDDC, CMD1A, CMT2B1, dilated 1A (autosomal dominant), EMD2, FPLD, HGPSFPL, lamin A/C, lamin A/C-like 1, lamin-A/C, LDP1, LFP, LGMD1B, limb girdle muscular dystrophy 1B (autosomal dominant), LMN1IDC, LMNC, LMNL1, prelamin-A/C, PRO1,70 kDa lamin, progeria 1 (Hutchinson-Gilford type), renal carcinoma antigen NY-REN-32 | |
| LMNA | |
| IgG2b | |
| Unpurified | |
| Detects lamin A/C from human, bovine and porcine samples. |
| mab636 | |
| Western Blot | |
| Unconjugated | |
| Mouse | |
| Human | |
| Q3ZD69 | |
| 4000 | |
| Porcine lamin preparation. | |
| Primary | |
| Store at -20°C. Avoid freeze/thaw cycles. |
For Research Use Only
Spot an opportunity for improvement?Share a Content Correction
Product Content Correction
Your input is important to us. Please complete this form to provide feedback related to the content on this product.
Product Title